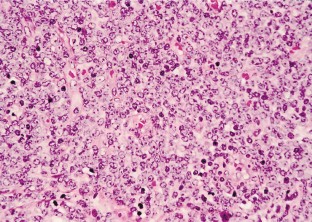

This is a preview of subscription content, access via your institution
Access options
Subscribe to this journal
Receive 12 print issues and online access
$259.00 per year
only $21.58 per issue
Buy this article
- Purchase on SpringerLink
- Instant access to the full article PDF.
USD 39.95
Prices may be subject to local taxes which are calculated during checkout

References
Neiman RS, Barcos M, Berard C, Mann R, Rydell RE, Bennett JM . Granulocytic sarcoma: a clinicopathologic study of 61 biopsied cases Cancer 1981 48: 1426–1437
Bird JC, Edenfield WJ, Shields DJ, Dawson NA . Extramedullary myeloid cell tumors in acute nonlymphocytic leukemia: a clinical review J Clin Oncol 1995 13: 1800–1816
Bennett JM, Catovsky D, Daniel MT, Flandrin G, Galton DAG, Gralnick HR, Sultan C . Proposal for the recognition of minimally differentiated acute myeloid leukaemia (AML-M0) Br J Haematol 1991 78: 325–329
Morishita K, Kubota N, Asano S, Kaziro Y, Nagata S . Molecular cloning and characterization of cDNA for human myeloperoxidase J Biol Chem 1987 262: 3844–3851
Traweek ST, Liu J, Braziel RM, Jhonson RM, Brynes RK . Detection of myeloperoxidase gene expression in minimally differentiated acute myelogenous leukemia (AML-M0) using in situ hybridization Diagn Mol Pathol 1995 4: 212–219
Rege K, Powles R, Norton J, Mahendra P, Mitchell P, Agrawal S, Mehta J, Treleaven J . An unusual presentation of acute myeloid leukemia with pericardial and pleural effusions due to granulocytic sarcoma Leuk Lymphoma 1993 11: 305–307
Astall E, Yarranton H, Arno J, Marcus R . Granulocytic sarcoma preceding AML M0 and the diagnostic value of CD34 J Clin Pathol 1999 52: 705–707
Suzuki R, Yamamoto K, Seto M, Kagami Y, Ogura M, Yatabe Y, Suchi T, Kodera Y, Morishima Y, Takahashi T, Saito H, Ueda R, Nakamura S . CD7+ and CD56+ myeloid/natural killer cell precursor acute leukemia: a distinct hematolymphoid disease entity Blood 1997 90: 2417–2428
Ferrari S, Mariano MT, Tagliafico E, Sarti M, Ceccherelli G, Seleri L, Merli F, Narni F, Donelli A, Torelli G, Torelli U . Myeloperoxidase gene expression in blast cells with a lymphoid phenotype in cases of acute lymphoblastic leukemia Blood 1988 72: 873–876
Acknowledgements
We wish to thank Mr Yoichi Tani and Mr Koichiro Kitagawa (Dako Lab, Dako Japan) for their valuable assistance with the in situ hybridization for MPO.
Author information
Authors and Affiliations
Rights and permissions
About this article
Cite this article
Miyazato, H., Sono, H., Naiki, Y. et al. Detection of myeloperoxidase gene expression by in situ hybridization in a case of granulocytic sarcoma associated with AML-M0. Leukemia 15, 1797–1799 (2001). https://doi.org/10.1038/sj.leu.2402270
Received:
Accepted:
Published:
Issue date:
DOI: https://doi.org/10.1038/sj.leu.2402270